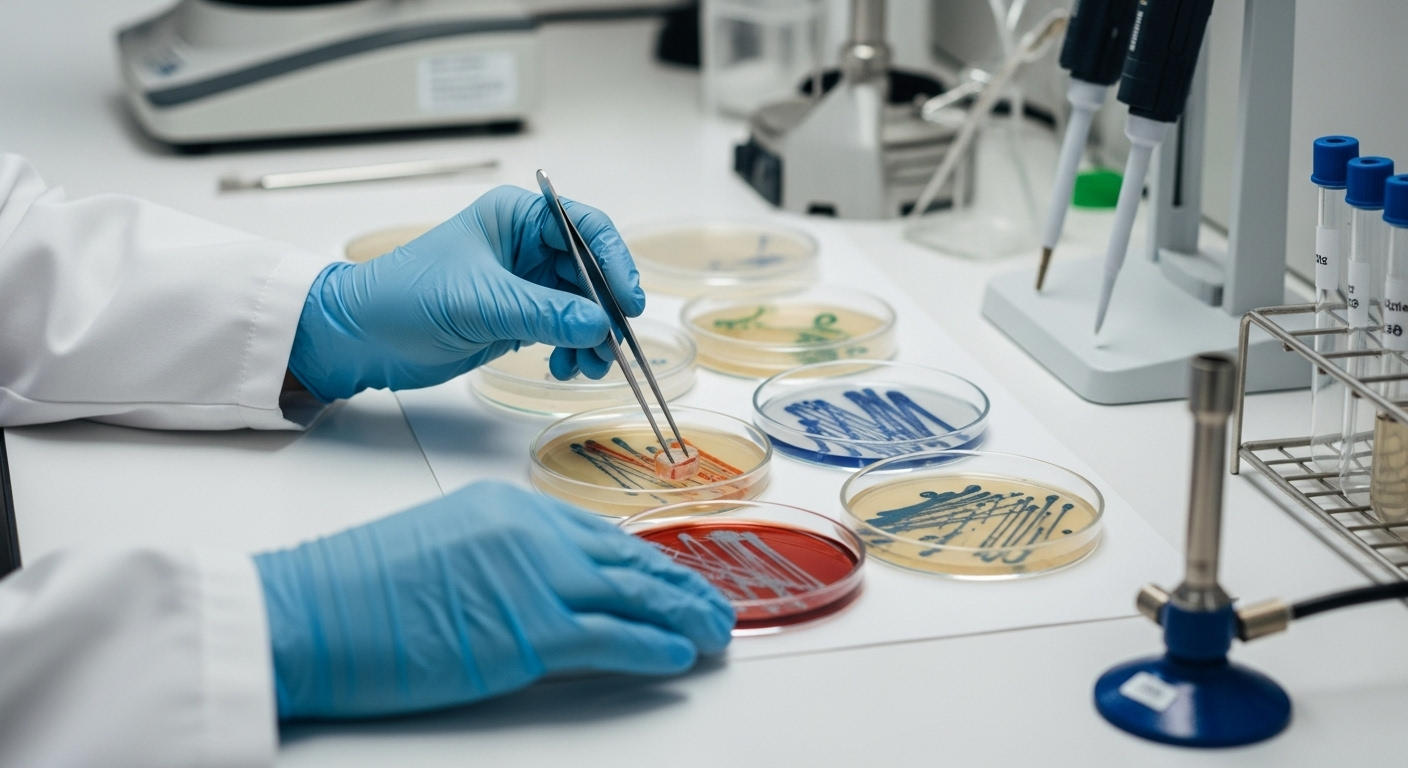

Anti-cancer : ce légume méconnu pourrait éliminer des cellules cancéreuses, selon une étude
Auteur: Adam David
Et si un simple légume pouvait nous aider dans la lutte contre le cancer ? C’est la question que tout le monde se pose après la publication d’une étude vraiment étonnante dans la très sérieuse revue Science. Des chercheurs ont découvert qu’un composant présent dans certains légumes verts pourrait littéralement « tuer des cellules cancéreuses » et ainsi freiner la maladie. Pour l’instant, soyons clairs, les tests n’ont été faits que sur des animaux, mais c’est une piste qui redonne beaucoup d’espoir, notamment contre une maladie qui touche beaucoup d’hommes.
Le cancer de la prostate, un ennemi bien connu des hommes

Parlons-en, du cancer de la prostate. C’est le cancer le plus fréquent chez les hommes en France. Il faut se rendre compte que c’est une maladie qui cause plus de 8 500 décès chaque année. Elle touche la prostate, une petite glande importante pour le système reproducteur masculin. Heureusement, dans beaucoup de cas, on arrive à le soigner. Le problème, c’est quand certains cancers deviennent résistants aux médicaments. C’est là que les scientifiques cherchent de nouvelles solutions.
On sait déjà que certaines habitudes peuvent augmenter les risques : une alimentation trop grasse, manger trop de viande rouge, le tabac, ou même avoir des cas dans sa famille. À l’inverse, bien manger, avec beaucoup de fruits et de légumes, ça aide. Et c’est justement dans cette direction que la nouvelle découverte est si intéressante.
La surprise des scientifiques : une vitamine qui agit différemment

Les chercheurs du Cold Spring Harbor Laboratory ont mis le doigt sur quelque chose de fascinant. Ils ont testé un composé appelé ménadione. C’est en fait une sorte de vitamine, la vitamine K3. Avant, on avait essayé avec d’autres vitamines, comme la vitamine E, sans grand succès. Mais la ménadione, elle, fonctionne tout à fait différemment.
Pour faire simple, on pense souvent aux « antioxydants » qui protègent nos cellules. Eh bien, la ménadione fait le contraire : c’est un « pro-oxydant ». Au lieu de protéger, elle attaque. Mais la bonne nouvelle, c’est qu’elle semble s’attaquer spécifiquement aux cellules cancéreuses. C’est un peu comme si, au lieu d’un bouclier, on avait trouvé une arme ciblée.
Comment ça marche ? les premiers tests sont prometteurs
Alors, comment ça fonctionne concrètement ? Les scientifiques ont mené leur expérience sur des souris atteintes d’un cancer de la prostate. Ils leur ont donné de la ménadione. Et les résultats ont été très nets.
La ménadione a en quelque sorte « affamé » les cellules cancéreuses. Elle a supprimé un lipide (une sorte de graisse) dont les tumeurs ont absolument besoin pour survivre et se développer. Sans cette graisse, les cellules cancéreuses sont affaiblies. Résultat : les chercheurs ont observé que la progression du cancer avait nettement ralenti chez les souris traitées. C’est une avancée majeure, même s’il faut le répéter : ces tests ont été faits sur des souris, pas encore sur des humains.
Où trouver ce bienfait ? les légumes à feuilles vertes

La question qu’on se pose tous : où trouve-t-on cette fameuse ménadione ? On ne la trouve pas facilement en complément alimentaire. Mais pas de panique, on la trouve sous une autre forme (la vitamine K1) dans des aliments très courants : les légumes à feuilles vertes.
Voici une petite liste pour vos prochaines courses :
- Les épinards
- Le chou frisé (qu’on appelle aussi kale)
- La bette à carde
- Le brocoli
- La laitue romaine
- La roquette
En plus de ce potentiel bienfait, ces légumes sont de toute façon excellents pour la santé. Ils sont pleins de fibres, de minéraux, et ne font pas grossir. Une raison de plus pour en mettre dans son assiette !
un espoir à cultiver, en attendant la science

Alors, que doit-on retenir de tout ça ? D’abord, que la recherche avance et que c’est une nouvelle formidablement encourageante. Cette découverte pourrait, un jour, aider les hommes atteints d’un cancer de la prostate à un stade précoce.
Mais il faut rester prudent et patient. La prochaine étape, ce sont les essais sur les humains, et ça prend du temps. En attendant, il est crucial de comprendre que manger des épinards ne guérit pas le cancer. Cela ne remplace absolument pas un traitement médical prescrit par un docteur.
Voyons-le plutôt comme un rappel. Un rappel simple et puissant que prendre soin de ce que l’on mange, c’est prendre soin de sa santé sur le long terme. Et ça, c’est déjà une victoire.
Selon la source : aufeminin.com










